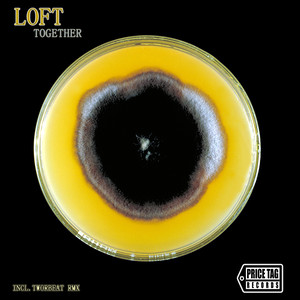
Charger

Loft
热门歌曲
-
Loft 3.45 MB 03:45
-
Loft 2.46 MB 02:41
-
Loft 3.49 MB 03:48
-
Loft 3.36 MB 03:40
-
Loft 2.81 MB 03:04
-
Loft 3.66 MB 03:59
-
Loft 3.75 MB 04:05
-
Loft 4.42 MB 04:49
-
Loft 3.52 MB 03:50
-
Loft 3.71 MB 04:03
-
Loft 2.9 MB 03:10
-
Loft 3.49 MB 03:48
-
Loft 4.93 MB 05:23
-
Loft 3.37 MB 03:41
-
Loft 5.52 MB 06:01
-
-
Loft 3.82 MB 04:10
-
Loft 2.82 MB 03:04
-
Loft 3.84 MB 04:11
-
Loft 5.89 MB 06:26
-
Loft 3.03 MB 03:18
-
Loft 3.87 MB 04:13
-
Loft 3.93 MB 04:17